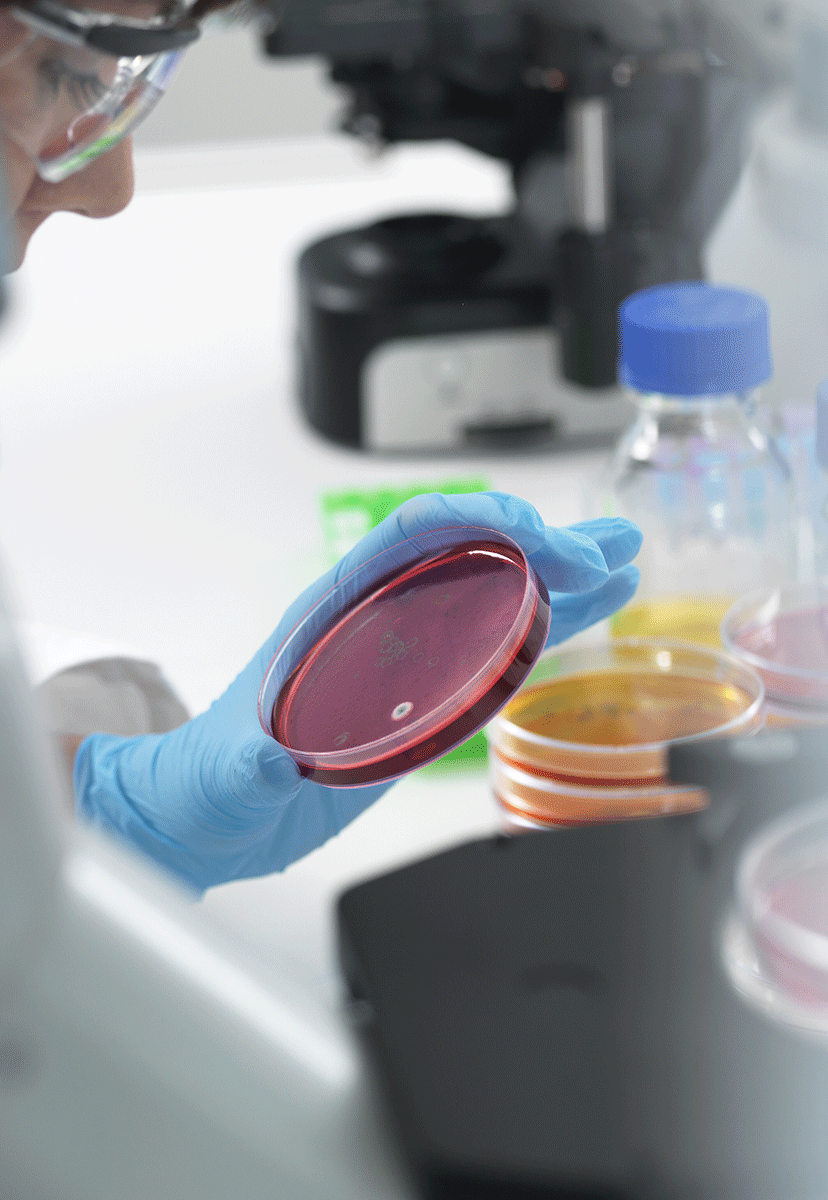
Live Cell Analysis

Track Etched Membrane is a high-precision manufactured film used in critical applications for Life Sciences, automotive, industrial and consumer markets.
Specified pore diameter is tight, with each pore associated with a single channel through the membrane.
GVS is the leading manufacturer and supplier of the PCTE (Poly Carbonate Track Etched) and PETE (Polyester Track Etched) membranes.
Features & benefits of Track Etched Membranes
- High range of chemical compatibility: resistant to a wide range of chemicals
- Smooth, thin, glass-like surface: captures all particles on the surface larger than the pore size
- Precise pore size and density: provides flow control for liquids moving through the membrane capturing 100% of cells larger than pore size
- Low extractable: ensures tests will be clean promoting consistent results
- Low protein binding: low binding prohibits absorption of cells being filtered
- Negligible absorption/adsorption: maximizes critical solution recovery
- Essentially zero auto fluorescence
The Track Etched Membrane is used in cell biology, microbiology, analytical testing, and other applications.
In the area of cell biology and biochemistry, cell cultures are used as model system to study the interaction between cell and disease causing by agents like bacteria, virus, to study the effect of drugs, the process of aging and also they are used to study triggers for ageing.
Hydrophilic PCTE Membrane Filter Applications guidelines
- 0.01 - 0.1 µm: most liposome extrusions, asbestos, bacteria removal (Acholeplasma laidwaii), removal of colloidal material from water, mycoplasma removal, tissue culture with collagen (skin graft) and virus filtration
- 0.2 µm: general sterile filtration, cell culture, sterile filtration of corrosive fluids, immunology, implant tissue and cell studies, air venting, aqueous fluids, air and gas sterilizing. FITC stain technique, Legionella pneumophilia - air-conditioning water, DNA fragments filtration, phytoplankton, bacteria removal, deionized water-clinical laboratory Type 1 and for semiconductor industry using SEM analysis, and EPA leachate/toxicity testing
- 0.4 µm: sterility testing, pulp, paper-absorbable organic halides-water (AOX), air (asbestos fibers, silica particles pollen), dewatering, purification of cellular suspensions and wine stabilization, immunology - tissue and cell studies, forensic analysis (SEM), microscopic examination - samples, Water-pollution (Escherichia coli), trace metal analysis (USGS method), nitrates, nitrites, phosphates, and ammonia (low extractable), particle analysis of corrosive fluids, bacteria - Serratia marcescens, and cell culture
- 0.6 µm: particle analysis (corrosive fluids), analysis of wine, milk, cells and plasmapheresis and latex agglutination Assays
- 0.8 µm: general air analysis (asbestos, Cadmium), sugar molds (food), gravimetric analysis, tissue culture partitioning, wine stabilization, alkaline elution (DNA)
- 1.0 µm: serum pre-filtration, beer stabilization, ultra-cleaning (corrosive fluids), microfiltration (alcohol solutions), Giardia lamblia (removes most of them), red blood cells (RBC)
- 2.0 µm: chemotaxis, alkaline elution (DNA), red blood cells (RBC's)
- 3.0 µm: general microfiltration and clarification, cytological evaluation (cerebrospinal fluid), chemotaxis, red blood cells (RBC), microfiltration of corrosive fluids
- 5.0 µm: exfoliate cytology, chemotaxis, gravimetric analysis, Gairdia lamblia (3-5um) observation, canine heartworm microfilariae (dirofilaria immitis), erythrocyte deformability (4.7 µm), gross particulate analysis of corrosive fluids (oil, diesel, gas filtration)
- 8.0 µm: cytology
- 12.0 µm: starch, Schistosoma haematobium
- 8.0 - 14.0 µm: larger bacteria, general clarification and pre-filtration of corrosive fluids, most acids, some ester photoresists, reagent grade chemicals and alcohol solutions
- 10.0 - 12.0 µm: Human melanoma invasion study (cancer-tumors), leukocytes, metastasis tumor cell.
For additional information, please visit:
Polyester Track Etched PETE Membrane
***
Kuber Singh, Sales Manager, GVS USA
Michele Monna, BDM LS Southern Europe, GVS Italy